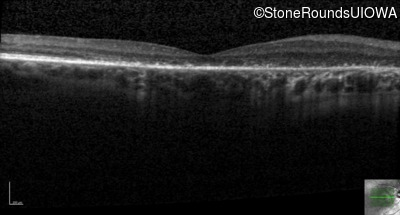
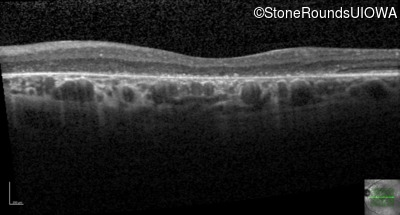
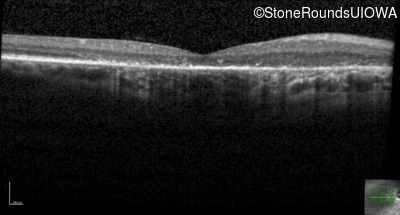
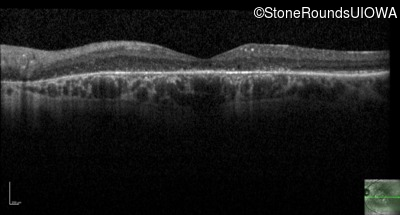
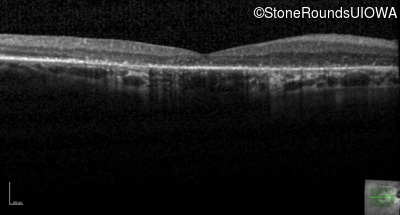
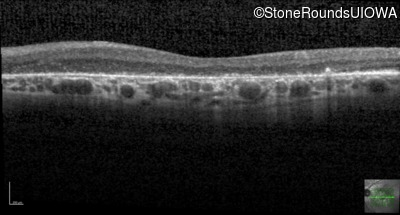
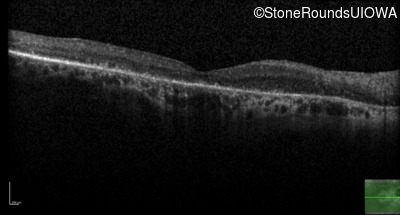
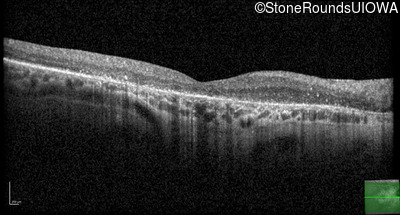
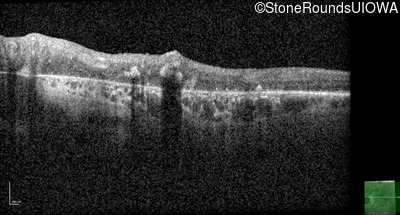
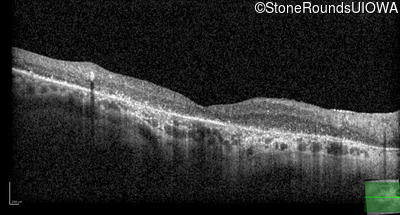
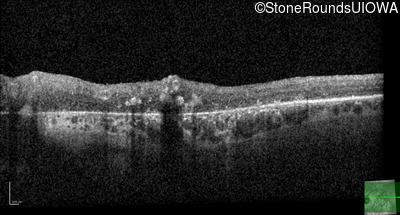

Case
SR251
Student Mode
Cone-Rod Dystrophy (IA1b)
Female
Female
Hidden
SR251
Student Mode
Cone-Rod Dystrophy (IA1b)
Female
Female
History
This 58 year old woman first noticed a gap in the vision of her left eye at age 46.
| Age at visit: 58 years |
| Age at visit: 60 years |
| Age at visit: 64 years |
| Age at visit: 66 years |
| Age at visit: 68 years |
Diagnosis & molecular findings
| Disease | Gene | Allele 1 variant(s) | Allele 2 variant(s) | Inheritance mode |
|---|---|---|---|---|
| Cone-Rod Dystrophy | CRB1 | Cys948Tyr (T)GT>(T)AT | Asp165 del9cagGATGGAATT | AR |
Disease:
Gene:
Allele 1:
Cys948Tyr (T)GT>(T)AT
Allele 2:
Asp165 del9cagGATGGAATT
Inheritance:
AR